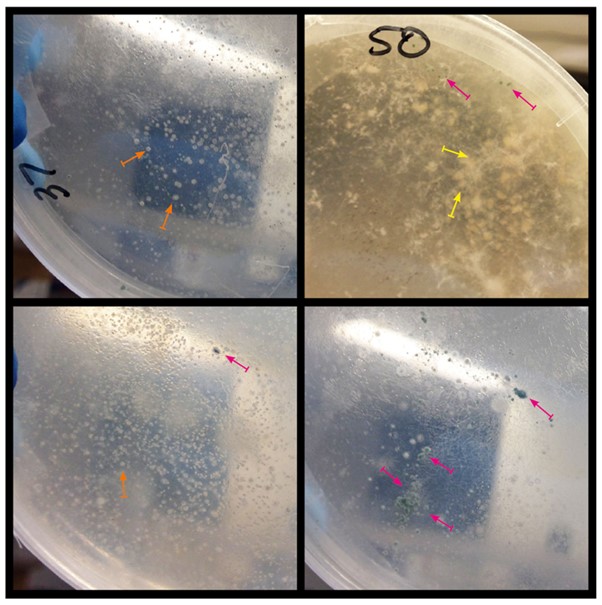
Photos of microbial growth on plates with target chemicals

GISERA Newsletter, February 2020


Welcome to 2020, the start of a new and challenging decade. The role gas has to play in the energy transition is critical and, more than ever, communities, industry and government bodies alike recognise the need for impartial and rigorous scientific research on onshore gas development.
This issue of the GISERA newsletter reflects on some of GISERA's research achievements since its beginning in 2011, and looks forward to new research opportunities in South Australia and the Northern Territory.
In other news, one of the key events for GISERA is our annual Stakeholder Roundtable Group meeting, which brings together important groups representing a range of interests, activities and views related to Australia's onshore gas industry. We held our third meeting in Canberra in November, and I would like to thank attendees and guest presenters for making it a very successful and productive meeting.
GISERA places great importance on the feedback and direction we gain from our stakeholders at these meetings. They allow us the opportunity to understand the diversity of views and priorities of involved government departments, universities, councils, institutes, industry bodies and resource companies.
GISERA had a busy finish to 2019, with the last couple of months focusing on finalising existing projects and defining new research opportunities for 2020 and beyond. Some of these opportunities are identified during engagement activities like the Stakeholder Roundtable, which recently highlighted the need for improved information and data on fugitive and other greenhouse gas emissions.
Wishing you all a very good start to the new year (and the new decade).
Regards
Dr Damian Barrett
GISERA Director

The Gas Industry Social and Environmental Research Alliance was founded in July 2011 and membership now comprises CSIRO, Australia Pacific LNG (APLNG), QGC, Santos, Origin Energy and, more recently, Pangaea Resources. The Australian Government's Department of Industry, Science, Energy and Resources; New South Wales Government; South Australian Government; Queensland Government; and Northern Territory Government are all funding contributors.
The alliance was first formed to investigate social and environmental impacts and research opportunities of onshore natural gas projects. The purpose of GISERA, both past and present, is for CSIRO to provide independent and quality-assured scientific research, focusing on social and environmental topics, for the benefit of all Australian communities living in gas development regions. Our research over the past decade has covered a range of sites, community concerns and science disciplines. Since 2011, GISERA has engaged CSIRO scientists in more than 50 research projects across seven focus areas - surface and groundwater; agricultural land management; greenhouse gases and air quality; social and economic issues; health impacts; terrestrial biodiversity and the marine environment.
Water has been, and remains, a major focus. An early GISERA project investigated the impacts of the re-injection of treated CSG water into the Precipice Sandstone aquifer in the Surat Basin, Queensland. Re-injection of treated CSG water is a valuable method for managing CSG impacts on water resources, protecting springs and riverine ecosystems, and allowing innovative reuse of water - with benefits to the wider community. Results of this research provided important technical and operational guidance to APLNG as the company established Australia's largest treated CSG water re-injection scheme at Reedy Creek. Operated by Origin Energy, the Reedy Creek scheme came online in 2015 and, to date, has re-injected 2,500 ML of treated CSG water into the Precipice Sandstone aquifer. Origin reports that aquifer levels have risen by approximately 30m close to the injection site and increases of over a metre have been monitored almost 100km from the site.
As we move forward, GISERA projects continue making progress across NSW, QLD, SA and the NT. For instance, new work in the NT has focused on accumulating baseline data before gas development takes off in the region - including collecting data on methane emissions, groundwater properties, and stygofauna and microbial assemblages in groundwater-dependent ecosystems. Baseline data is crucial for the ongoing monitoring of the potential impacts of gas development.
These are just a few examples. Looking ahead, we have new projects, proposals and research needs across the range of GISERA's social and environmental focus areas. We are excited to continue working on science and innovation with our members, collaborators and communities living in gas development regions.
Photo above: An injection well at Australia Pacific LNG's Reedy Creek treated water re-injection scheme (image courtesy of Origin Energy).

GISERA held its third annual Stakeholder Roundtable Group (SRG) meeting in Canberra in November 2019, providing a forum for discussion on key developments in the Australian onshore gas industry. Highlights this past year were CSIRO's role in contributing relevant scientific information about methane emissions and greenhouse gases in Australia, and recognition of CSIRO and GISERA's contributions to emission science in Australia.
Attendees represented federal departments (Department of Industry, Science, Energy and Resources (DISER); and Department of Environment and Energy (DEE)); the Grattan Institute; Minerals Council of Australia; Central and Northern Land Councils; the Australia Institute; Australian National University; industry (Origin, APLNG, Santos, Shell/QGC); and CSIRO.
Guest speaker Graeme Bethune, Chief Executive Officer from Energy Quest, presented a detailed overview of the onshore gas industry. A presentation by guest speaker Rob Sturgiss, Assistant Secretary, National Inventory Systems and International Reporting Branch (DEE), provided perspectives on greenhouse gas emission accounting.
CSIRO scientists presented the latest research finding on greenhouse gas emissions, focusing on baseline methane measurements in the Northern Territory and New South Wales, lifecycle assessment of greenhouse gas emissions from a Queensland CSG-to-LNG project, and methane regional fluxes in the Surat Basin.
Various aspects of the onshore conventional gas industry in south east South Australia (Limestone Coast Region) were presented at a GISERA Knowledge Transfer Session held in Adelaide in November last year.
Eighteen people attended the session, representing Primary Industries and Regions South Australia, Department for Energy and Mining, SA Environment Protection Authority, Department of Environment and Water, and CSIRO.
CSIRO researchers presented findings on microbial degradation of gas chemicals in South Australian soils and water, conventional gas impacts and opportunities for South Australian primary producers, and exploration of future conventional gas development scenarios for regional industries.
Feedback from participants recognised the wide diversity of views on conventional gas in the south east of South Australia and, in particular, the importance of protecting regional groundwater resources.
Photos above: Microbial growth on plates with target chemicals. Top left: untreated; Top right: pristane; Bottom left: naphthalene; Bottom right: xanthan gum. Magenta arrows show green conidia on small fungal colonies; yellow arrows show thick, white, unevenly margined colonies; orange arrows show examples of bacterial colonies.

GISERA has two new research projects in the Northern Territory, which will focus on well integrity in line with recommendations of the Scientific Inquiry into Hydraulic Fracturing in the Northern Territory.
One project investigates options for long-term monitoring of well integrity in decommissioned onshore gas wells. Knowledge developed through this project will assist in the development of long-term well monitoring techniques and technologies to support best practice in onshore gas well decommissioning activities in the NT.
A second project draws on CSIRO's extensive materials science expertise to evaluate techniques and assess new materials designed to minimise fugitive methane emissions leaks caused by microfractures and gaps in gas well cement casing. Results of this project will help reduce fugitive methane emissions by improving the integrity of gas wells through the development of effective materials and best-practice techniques for sealing microfractures and micro-annuli in well-casing cement.
These projects are co-funded by the CSIRO, the Federal and NT governments, and resource companies Origin, Santos and Pangaea Resources.

The latest progress report for the Baseline assessment of groundwater characteristics in the Beetaloo sub-Basin project has been released. The report describes completed geochemical analysis work and provides a snapshot of groundwater geochemistry. It provides results of a groundwater sampling program carried out in October-November 2018 and a comparison with a CSIRO groundwater survey conducted in 2017.
The sampling program found:
Based on the June 2015 - November 2018 monitoring results, groundwater within the permit areas is suitable for irrigation and livestock purposes. Three monitoring bores were found to have naturally occurring radionuclide concentrations that exceed the World Health Organisation guidelines (2017) for drinking water quality and require further investigation for identification of individual radionuclides.
This study contributes to the understanding of the recharge mechanism of the Cambrian Limestone Aquifer in onshore gas exploration permit areas. The baseline groundwater sampling program is part of a suite of GISERA studies being undertaken in the NT, in line with the recommendations of the March 2018 final report of the Scientific Inquiry into Hydraulic Fracturing in the NT.
Results of these studies are important for informing appropriate policy and management responses to shale gas development proposals. GISERA researchers also helped draft technical work for the Strategic Regional Environmental Baseline Assessment (SREBA) in the Northern Territory, which is now out for public consultation.

We have some exciting new projects beginning in the Northern Territory:
To view a list of all GISERA projects and learn more about our research, visit our website.
Don't have time to read a detailed report? GISERA provides a fast track to the latest news and research project progress with clear, concise and easy-to-read fact sheets.
Here's the latest from the GISERA website:
